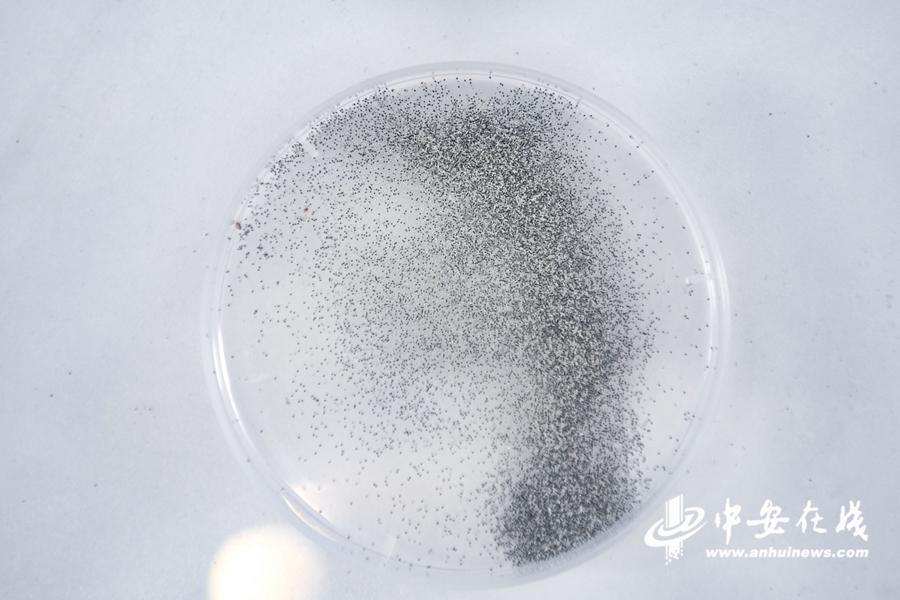

【长三角网媒看安徽】看郑蒲港新区的工业发展“加速度”
中安在线、中安新闻客户端讯 2022年,马鞍山市地区生产总值2521亿元,增长4.6%,位居安徽省第3位、长三角第5位。7月13日上午,长三角三省一市网络媒体联合采访组一行来到马鞍山市郑蒲港新区。

在落实皖江承接产业转移示范区国家战略、推进跨江联动发展的背景下,郑蒲港新区于2012年1月4日成立,总面积达225平方公里。
“我们现有博士30余人,博士后1人。”马鞍山南大高新技术研究院相关负责人介绍,目前正在研究超高纯银、金和铅的制备和高可靠性胶黏剂的开发。该研究院是由郑蒲港新区与南京大学合作创办的“政、产、学、研”科技创新平台,依托南京大学科技人才优势与郑蒲港新区产业特色,建设集“科技开发、成果转化、科技孵化”于一体的科技创新平台。研究成果在新区实现产业化。


在郑蒲港新区,还有一家产值高达1.8亿元的电子科技公司——安徽富捷电子,这是一家集厚膜贴片电阻设计开发、生产、销售于一体的民营独资企业。“第一期电阻产能每月可达100亿颗,计划到2024年底每月产能达600亿颗。”公司行政总监贺海俊介绍,安徽富捷电子具有国际专业的厚膜贴片电阻研发核心技术团队和遍及全球的销售网络,今年上半年产值约为1亿元。

“去年产值0.27亿元,今年上半年产值为5000万元。”安徽国洁新能源生产部经理狄军伟说。该公司研发、制造功率型锂离子电池新能源产品,适用于无线电钻、园林工具、电动单车、无人飞机以及新能源电动汽车等领域。公司采用国际领先的第八代智能制造技术,年生产能力达1亿支,产品主要销往广东、浙江、江苏等地。




除了已投产的企业,郑蒲港新区还有在建中的未来新星。
在中联重科智能装备制造产业园,工人们正在热火朝天地赶工期。这座总投资60亿元、总建筑面积50万平方米的工厂将于今年年底建成,投入使用后预计年产旋挖钻机、掘进机、桩机等智能工程机械5000台,预计年销售收入达150亿元。




如今郑蒲港新区发展水平已进入安徽省开发区先进行列。今年前三季度,新区顺利签约工业项目47个,总投资223.7亿元。

今年,新区将紧扣“双招双引”与“制造业倍增”两个关键词,重点围绕已落地的中联重科、中南光电、瑞声科技等龙头企业开展产业链招商,发挥综保区、自贸联动创新区、跨境电商等多平台叠加优势,在招大引强上再发力。力争在去年已签约51个重点招商项目的基础上,加快项目洽谈进展,确保全年引进20亿元以上项目5个、50亿元以上项目1个,力争签约1个百亿元项目。(记者 徐慧冬 檀美玲 段玉 赵艾凌 王成光 周起刚 实习生 侯敏 吴亚男 席佳成)






